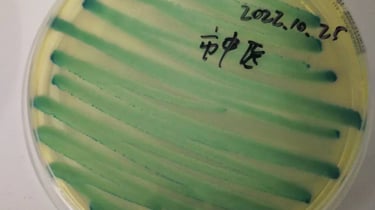

Re:invent Health Care
As a passionate advocate for advancing healthcare accessibility, I founded Re:Invent Health Care with the vision of transforming rapid diagnostics. Our mission is to empower individuals by providing high-quality, affordable, and reliable point-of-care tests—making health monitoring easier, faster, and more accessible.
Re:Invent Health Care is dedicated to enabling individuals to monitor their reproductive health through easy-to-use self-diagnostic solutions, ensuring privacy, confidence, and control over their well-being. I firmly believe that everyone should have the tools to manage their health—anytime, anywhere.
Seize control of your health. Let’s work together for a healthier future!


Our Services
Point-of-care testing designed for women's health and comfort
Quick Results
Get accurate test outcomes within minutes, no waiting required.


Easy Sampling
Minimal sample preparation ensures a hassle-free testing experience.


Common Genital infections
Trichomonas Vaginalis
Candida albicans Yeast

Gardnerella vaginalis
Candida albicans, a fungal infection which causes vulvovaginitis candidiasis, and bacterial vaginosis are the other 2 most common causes of abnormal vaginal discharge, which are not considered to be STIs, despite the potential for transmission between sexual partners.
Trichomoniasis, caused by the protozoan Trichomonas vaginalis, is the most common non-viral STI worldwide, is one of the most common causes of abnormal vaginal discharge and can lead to urethritis.
BV is associated with an increased risk of gynaecological and obstetric sequelae, including preterm delivery and spontaneous abortion, as well as an increased risk of acquisition and transmission of HIV and other STIs . Gardnerella spp. are key founder organisms in BV, displaying the greatest propensity to adhere to vaginal epithelial cells and initiate biofilm formation.
Trichomonas | Candida | Gardnerella


Diagnostic Challenges
Several challenges remain in the diagnosis of T. vaginalis infection in routine clinical practice:
• Low sensitivity of traditional microscopy
Wet mount microscopy is commonly used but has limited sensitivity, typically ranging from 51–65%, which may lead to missed infections.
• Time-sensitive sample examination
Microscopic examination must be performed within 10–20 minutes after sample collection, as the parasites rapidly lose motility, reducing diagnostic accuracy.
• Dependence on operator expertise
Microscopy results are highly dependent on clinical experience and interpretation, which may introduce variability between laboratories and clinicians.
• Limited accessibility of advanced molecular tests
While NAAT-based assays provide higher sensitivity, they require laboratory infrastructure, specialized equipment, and longer turnaround times.
• Asymptomatic infections
Many T. vaginalis infections are asymptomatic, meaning infections may remain undetected without appropriate diagnostic testing.
• Sampling limitations
Traditional diagnosis often relies on vaginal swab specimens, while awareness of urine-based detection options remains limited in some clinical settings.Write your text here...
Stay Informed
Get updates on women's health testing
Help
Questions? Reach out anytime.
Contact
Connect
hello@reinventhealthcare.eu
© 2025. All rights reserved.
